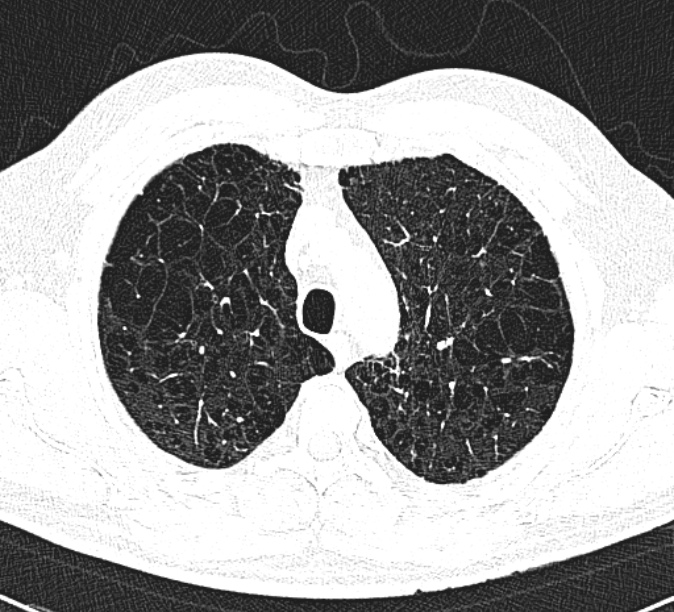

Most people have heard of asthma and lung cancer, but another condition — Chronic Obstructive Pulmonary Disease (COPD) — is one of the leading causes of death worldwide. Despite its prevalence, many people don’t know what COPD actually is, how it develops, or what can be done about it.
In this article, we’ll demystify COPD, explaining what it is, why it occurs, how it affects daily life, and what steps people can take to prevent or manage it.

Chronic Obstructive Pulmonary Disease is an umbrella term that covers two main problems:
Chronic bronchitis — long-term inflammation and narrowing of the airways, often causing a persistent cough with mucus.
Emphysema — damage to the tiny air sacs (alveoli) in the lungs, reducing the lungs’ ability to exchange oxygen.
In modern respiratory medicine, all of the terms “COPD”, “Emphysema” and to a lesser extent “Chronic Bronchiolitis” are used interchangeably.
Together, these changes make it harder to get air in and out of the lungs. COPD is progressive, meaning it usually gets worse over time with continued smoking. But with the right care, its progression can be slowed, and symptoms can be managed.

Globally, COPD is the third leading cause of death.
In the UK alone, it affects about 1.3 million people (though many remain undiagnosed).It’s most common in people over 40, especially those with a history of smoking.Despite its scale, COPD doesn’t receive as much public attention as other major diseases — which is why awareness matters.
The main culprit is long-term exposure to irritants that damage the lungs.
Responsible for up to 80-90% of cases.Both current and former smokers can develop COPD.
Dust, fumes, and chemicals in workplaces (e.g., construction, mining, agriculture).Outdoor and indoor pollution (wood smoke, biomass fuel) also play a role. This is usually combined with smoking and genetics, and is more difficult to be the only cause of COPD.
A rare inherited condition called alpha-1 antitrypsin deficiency can predispose people to COPD, even if they’ve never smoked.

COPD develops slowly, which means people often ignore early symptoms or blame them on ageing. Common signs include:
As the disease progresses, symptoms worsen and can significantly limit daily activities.

Doctors usually confirm COPD with:
Early diagnosis is crucial. Many people only get diagnosed when their lung function is already severely reduced.
COPD affects more than just the lungs. People often experience:
This is why COPD isn’t just a “breathing problem” — it’s a condition that impacts nearly every part of life.

People with COPD are prone to sudden worsening of symptoms, known as exacerbations. These flare-ups are often triggered by infections or air pollution and can lead to hospital admissions. Signs of an exacerbation include:
Prompt treatment (antibiotics, steroids, oxygen, or hospital care) can save lives. Preventing flare-ups is one of the main goals of COPD management.
There is no cure, but many treatments can slow progression and improve quality of life.
The single most effective intervention. Even after years of smoking, quitting improves survival and slows decline.
Exercise classes and education sessions designed for people with COPD.Proven to improve fitness, reduce breathlessness, and boost confidence.
Flu and pneumonia vaccines reduce the risk of serious infections.
In advanced COPD, some people need long-term oxygen at home.
In rare cases, lung volume reduction surgery, valves or transplantation may be considered.

The most important steps are:
“Only smokers get COPD.”
False. Non-smokers can develop COPD, especially from pollution or genetics.
“Nothing can be done once you have it.”
False. While it can’t be cured, COPD can be managed effectively with the right care
“It’s just part of getting older.”
False. Breathlessness isn’t inevitable with age — it’s a warning sign.
COPD deserves more attention because:
By raising awareness, we can encourage earlier testing, smoking cessation, and better support for those living with the disease.
